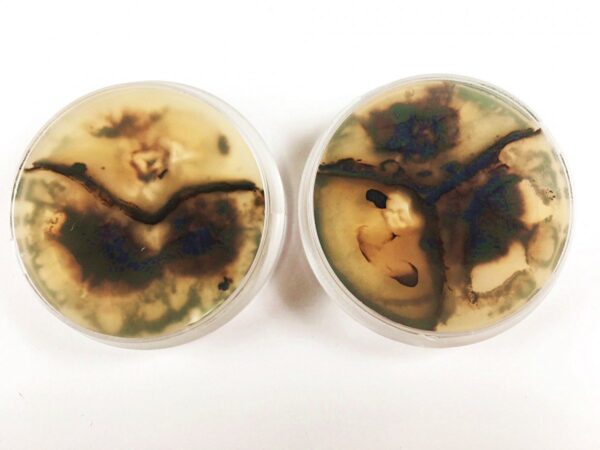

Holz ist ein beliebter Werkstoff für Möbelstücke. Je schöner es marmoriert ist, desto dekorativer macht es sich im Wohnambiente. Die faszinierenden Muster aus Farben und Linien stammen übrigens von Pilzen, die das tote Holz besiedeln. Schon seit der Antike ist beispielsweise die Trüffelbuche mit ihrer einzigartigen Holzmarmorierung ein gesuchter Rohstoff. Das Muster entsteht übrigens durch einen spontanen Schimmelpilzbefall. Das Auffinden eines solch exklusiven Trüffelstückes war bisher mit langen Wartezeiten und vor allem auch mit viel Glück verbunden.
Pilze lernen zeichnen
Doch Forscher der Empa-Akademie St. Gallen entwickelten nun ein Verfahren, das die Entstehung der Holzmusterung beschleunigt. Sie luden dafür kurzerhand die Pilze ins Labor ein und brachten ihnen dort das gezielte Zeichnen bei. „Wir konnten in der Natur wachsende Pilzarten identifizieren und analysieren, um jene mit den günstigsten Eigenschaften als Holzveredler auszuwählen“, so Empa-Forscher Hugh Morris von der Abteilung „Applied Wood Materials“.
Der Brandkrustenpilz etwa, oder die Schmetterlingstramete, hinterlassen mit dem Farbstoff Melanin pigmentierte schwarze Linien. Gleichzeitig bleichen sie das umliegende Holz dank ihres Enzyms Laccase aus.
So entsteht ein Muster mit besonders starkem Kontrast im Holz“, erklärt Morris.
Je nach Kombination der eingesetzten Pilzspezies gestalten sich die Linien mal wild und ungestüm oder auch geometrisch präzise. Dann wieder schlängeln sie sich unruhig aufeinander zu und trennen kleine Parzellen auf ihrem hellen Untergrund ab. An anderen Stellen fließen die dunklen Zeichnungen ruhig und gelassen als Mahnmal einer Grenze, die keiner der Beteiligten überschreiten mag.
Muster sind Demarkationslinien
Pilze tragen im Holz ein Gefecht um Territorium und Ressourcen aus. Dieses grenzt sich mit dunkel pigmentierten Linien deutlich voneinander ab. Die feinen Fäden der Pilzgemeinschaft schützen mit diesen Demarkationslinien ihre Kolonie zum einen vor anderen Pilzen. Zum anderen sorgt die Pigmentgrenze dafür, dass Bakterien und Insekten fernbleiben. Somit bleibt dem Lebensraum ein ideales Maß an Feuchtigkeit erhalten.
Besonders vorteilhaft an den im Empa-Labor verwendeten Pilzen ist deren sanfter Biss: Denn trotz des ausgeprägten Zeichentalents zernagen die ausgewählten Kandidaten ihren Untergrund kaum.
Das Holz wird zwar von den Pilzen großzügig mit Pigmenten versorgt, behält aber seine Stabilität und Form bei“, so der Biologe.
Harthölzer wie Buche, Esche und Ahorn eignen sich zur Behandlung mit den Pilzkulturen am besten. Dass der Prozess je nach gewünschtem Ergebnis gesteuert werden kann, liegt jedoch nicht nur an der Art der verwendeten Fäulniserreger. Die Forscher entwickelten zudem ein Verfahren, bei dem das Holz bereits innerhalb von Wochen zur Verarbeitung bereitsteht. Grund ist unter anderem, dass die gewählten Pilzarten bei deutlich geringerer Feuchtigkeit im Holz zur Tat schreiten. Daher muss der Rohstoff nach seiner Veredlung und vor der Verarbeitung zum Möbel nicht erst langwierig, kosten- und energieintensiv getrocknet werden.
Industriepartner fertigt Möbel
Gemeinsam mit der Koster Holzwelten AG in Arnegg (SG) arbeiten die Forscher nun daran einen effizienten und ökologisch nachhaltigen Produktionsweg zu implementieren. Hierzu gehört natürlich auch die Nutzung von regionalem Holz. „Buchenholz ist ein in der Schweiz häufiges, aber für Möbeldesigner uninteressantes Hartholz“, erklärt Koster. Mit Marmorholz aus einheimischer Buche könne man jedoch am Schweizer Holzmarkt, dessen jährlicher Umsatz rund drei Milliarden Franken betrage, gesuchte Produkte anbieten. Zusätzlich zu Möbeln, Parkettböden und Küchenfronten kann Marmorholz auch für dekorative Objekte und Musikinstrumente verwendet werden. Mit der neuen Technologie lassen sich diese Einzelstücke nun schneller, nachhaltiger und mit dem gewünschten Muster herstellen.
Doch die Forscher haben noch ein weiteres Ziel: Morris ist sich sicher, dass er den Pilzen demnächst sogar das Schreiben von Worten „beibringen“ kann.




